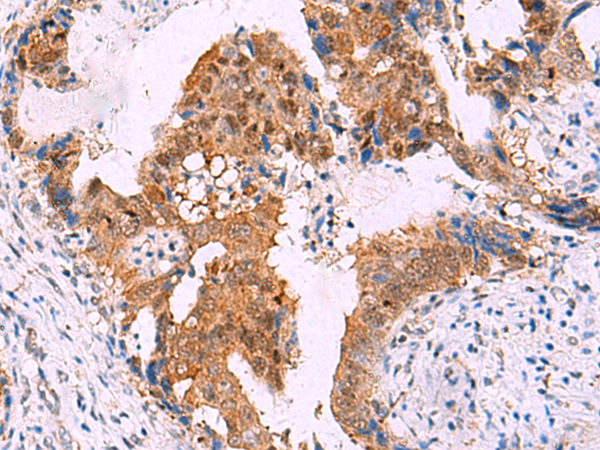
一抗

|
Background: |
The protein encoded by this gene is a member of the immunophilin protein family, which play a role in immunoregulation and basic cellular processes involving protein folding and trafficking. This encoded protein is a cis-trans prolyl isomerase that binds to the immunosuppressants FK506 and rapamycin. It has high structural and functional similarity to FK506-binding protein 1A (FKBP1A), but unlike FKBP1A, this protein does not have immunosuppressant activity when complexed with FK506. It interacts with interferon regulatory factor-4 and plays an important role in immunoregulatory gene expression in B and T lymphocytes. This encoded protein is known to associate with phytanoyl-CoA alpha-hydroxylase. It can also associate with two heat shock proteins (hsp90 and hsp70) and thus may play a role in the intracellular trafficking of hetero-oligomeric forms of the steroid hormone receptors. This protein correlates strongly with adeno-associated virus type 2 vectors (AAV) resulting in a significant increase in AAV-mediated transgene expression in human cell lines. Thus this encoded protein is thought to have important implications for the optimal use of AAV vectors in human gene therapy. The human genome contains several non-transcribed pseudogenes similar to this gene. |
|
Applications: |
ELISA, WB, IHC |
|
Name of antibody: |
FKBP4 |
|
Immunogen: |
Fusion protein of human FKBP4 |
|
Full name: |
FK506 binding protein 4 |
|
Synonyms: |
HBI; p52; Hsp56; FKBP51; FKBP52; FKBP59; PPIase |
|
SwissProt: |
Q02790 |
|
ELISA Recommended dilution: |
5000-10000 |
|
IHC positive control: |
Human cervical cancer |
|
IHC Recommend dilution: |
50-300 |
|
WB Predicted band size: |
52 kDa |
|
WB Positive control: |
231 and HepG2 cell lysates |
|
WB Recommended dilution: |
1000-5000 |


 購(gòu)物車
購(gòu)物車 幫助
幫助
 021-54845833/15800441009
021-54845833/15800441009